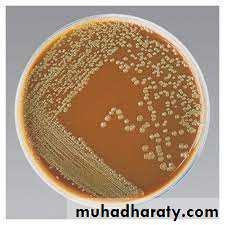
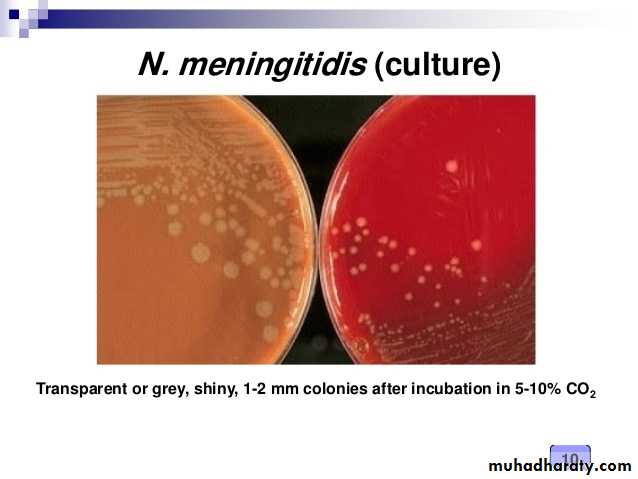

Neisseria
By Faten Naeem AbbasNeisseria
Of the eleven species of Neisseria that colonize humans, only two are pathogenic for humans:Neisseria gonorrhoeae (called gonococcus), the causal agent of gonorrhea.
Neisseria meningitidis (called meningococcus), the causal agent of meningitis.
• Both of them are G - , diplococci, aerobic , nonmotile , oxidase positive , that cannot be distinguished from each other under the microscope, but by sugar fermentation in laboratory (maltose, sucrose, and glucose) and the sites of their primary infections.
• Also both of them are classified as pyogenic cocci because infections by these organisms are characterized by the production of purulent (pus like) material comprised largely of W.B.C.
N. gonorrhoeae
Gonococci are noncapsulated (unlike meningococci) piliated, and nonmotile, and looks like a pair of kidney beans (figure).This species can cause 2 types of infections include :-
A-Venereal infection : gonorrhoea which is transmitted by sexual contact.
B- Non-venereal infection : Ophthalmia neonatorum is transmitted by contamination of infant's eye during labor through the birth canal of a gonorrhoeal mother and vulvo-vaginitis in small girls through contaminated toilet seats & contaminated towels.
Antigenic structures of Neisseria:
1- Pili : enhance attachment of the organism to host epithelial and mucosal cell surfaces and confer resistance to phagocytosis, as the most important virulence factors. Pilli are also antigenic.2- Lipooligosaccharide (LOS) : have shorter, more highly branched, nonrepeat O -antigen side chains than do lipopolysaccharides (LPS) found in G –B . In normal human serum , IgM directed against LOS antigens.
3- Outer membrane proteins (OMPs) : OMPI, functioning as a porin incomplex with OMP11 , OMP11 1 (called opacity protein) because itspresence renders gonococcal colonies les s translucent. OMP11 with pilli,mediates attachment of the organism to a host cell. Because of OMP 11’sability to antigenic variation, it also make the organism to evade the immune response and cause repeated infections.
4- IgA protease : cleaves IgA on mucosal surfaces (virulence factor)
Pathogenesis:
Pilli and OMP11 facilitate adhesion of the gonococcus to epithelial cells of the urethra, rectum, cervix, pharynx, conjunctiva, and make colonization possible. Pilli also enable the bacteria to resist phagocytosis. OMP 11’s ability to cause repeated infections.Both gonococci and meningococci produce an IgA protease that cleaves IgA1 to escape immunoglobulins of this subclass.
Clinical Significance:
Symptoms of infection with N. gonorrhoeae differ depending on the site of infection.Infection of the genitals can result in a purulent (or pus-like) discharge from the genitals which may be foul smelling, inflammation, redness, swelling, dysuria and a burning sensation during urination.
It’s colonize the mucous membrane of the genitourinary tract orrectum , cause a localized infection with the production of pus or may lead to tissue invasion, chronic inflammation, and fibrosis.
A higher percentage of females than males are generally asymptomatic,
More than one sexually transmitted disease may be acquired at the same time, e.g. gonorrhea with syphilis, Chlamydia, human immunodeficiency virus (HIV), hepatitis B virus, so need treatment for more than one pathogen.
1- Genitourinary tract infections:
In males → more acute and easier to diagnose. The patient presents with a yellow, pus urethral discharge and painful urination.
In females → infection occurs in the endocervix and extends to the urethra and vagina. A greenish -yellow cervical discharge is most common accomparied by intermenstrual bleeding, and may progress to the uterus, causing inflammation of the fallopian tubes, pelvic inflammatory disease and fibrosis (Infertility occurs in 20% of woman).
2- Rectal infections: Prevalent in male homosexual .
3- Pharyngitis: Is contracted by oral – genital contact.
4- Ophthalmia neonatorum: Is an infection of the conjunctival sac that is acquired by a new born during passage through the birth canal of a mother infected with gonococcus, if untreated lead to blindness.
5-Disseminated infection: Most strain of gonococci have a limited ability to multiply in bloodstream, therefore bacteremia is rare (in contrast, meningococci multiply rapidly in blood). Gonococcal infection is the most common causes of septic arthritis in sexually active adults. Disseminated infection are seen in both male and female, but are more common in female particularly during pregnancy and menses.
Laboratory identification:
Haematological investigation:a. Total leukocyte count shows leukocytosis.
b. Differential leukocyte count shows increase in polymorphnuclear cells.
Bacteriological examination:
Microscopical examination :
Gram's staining of smear from pus discharge (urethra , cervix . .. etc) shows G- diplococcus, observed inside polymorphonuclear leukocytes of clinical samples , piliated, non-capsulated and nonmotile (Figure).
Fluorescent antibodies technique is specific and sensitive method ,in male sample of discharge is collected for culture and smear/ in female besides urethral discharge cervical swab should also be studied.
Macroscopical examination :
• This perform on blood agar or chocolate agar or Thayer-Martin medium incubated in 5% CO2 . The colonies are non haemolytic , non-pigmented or gray in color , smooth , circular , small & convex.In chronic cases when mixed infection is usual, it is better to use selective medium the Thayer Martin medium.
While in case of chronic gonorrhoea , in male , the morning drop of discharge or prostatic secretion after massage can be examined as before. In female , cervical swab may give positive results .
Biochemical tests = oxidase + ferments glucose , but not maltose.
Serological test = Serum and genital fluid contain IgA and IgM antibodies against gonococcal pili, OMPs and LOS. The methods as:
Complement fixation test (CFT):it become positive 2 weeks after infection and remains positive for long time even after the cure of disease .
Flocculation test: it is simpler test than CFT.
Radioimmunoassay and ELISA. However; these tests lack specificity and reliability as diagnostic aid.
Nucleic acid probe: it may be used to detect gonococci in urethral and cervical specimen.
Treatment and Prevention
More than 20% of N. gonorrhoeae are resistant to: penicillin, tetracycline, cefoxitin, and \or spectinomycin. Penicillin – resistant organisms are called PPNG - (penicillinase producing N. gonorrhoeae ), which contain plasmids that carry the gene for β-lactamase, such as in Eschenchia coli and Haemophilas influenzae.Most organisms still respond to treatment with third generation cephalosporins → intramuscular dose of ceftriaxone for uncomplicated gonococcal infection of the urethra, endocervix or rectum.
Spectinomycin for patients who are allergic to cephalosporins.
Doxycycline, a tetracycline effective against Chlamydia and gonococci.
In ophthalmia neonatorum ,treatment is with erythromycin to eliminate Chlamydia trachomatis if present.
In disseminated infection with Chlamydia, a seven day course of doxycycline to eliminate infection.
Prevention depends on
(1) safe sexual practices
(2) treatment of the pregnant mother with antibiotics prevents ophthalmia neonatorum .
Neisseria meningitidis
It is G - diplococcus, like a kidney bean, appears in pairs (Figure) , nonmotile , piliated , attach to the nasopharyngeal mucosa .When meningococcus is isolated from blood or spinal fluid, it is capsulated, the most important virulence factor.This bacterium mainly cause cerebrospinal meningitis but it also can cause pharyngitis , adrenal haemorrhages & rarely myocarditis , the infection transmitted from the patient or carrier by droplets of nasopharyngeal secretions .
1- Serogroups
The LOS capsule is allow the identification of at least 14 capsular polysaccharide types called serogroups (A, B, C, W and Y) although approximately 90% of meningococcal disease are caused by serogroups A, B and C (serogroup C is usually responsible for epidemics in developing counters).2-Serotypes
A second classification system called serotyping (1, 2 …. 20) that is based on the properties of OMP and LOS.
Epidemiology
Transmission occurs through(1) inhalation of respiratory droplets from a carrier or a patient in the early stages of the disease ,
(2) recent viral or mycoplasma upper respiratory tract infection
(3) active or passive smoking
(4) complement deficiency.
Pathogenic strains may invade the blood stream and cause systemic illness after an incubation period of 2 - 10 days.
Pathogenesis
Antiphagocytic properties of the meningococcal capsule aid in the maintenance of infection. LOS released during autolysis and bacterial cell division, is responsible for many of the toxic effect found in disseminated meningococcal disease.Like gonococci, it’s make an IgA protease that cleaves IgA 1 and helps the pathogens to evade Ig of this sub class .
Clinical significance
N. meningitidis initially colonizes the nasopharynx, resulting in a largely asymptomatic meningococcal pharyngitis. In young children and other individuals, it can cause disseminated disease, by spreading through the blood → leading to meningitis and / or septicemia.
• 1. Meningitis:
• The epithelial lining of the nasopharynx normally serves as a barrier to bacteria . Rarely, meningococci penetrate this barrier → enter blood stream then multiply.• If not severe, the patient may have only a fever and other nonspecific symptoms. Also, its can seed from the blood to other sites: e.g. brain barrier and infecting the meninges, multiply and induce an acute inflammatory response, resulting in a purulent meningitis. Joint symptoms and a petechial rash are also observed. Within several hours the initial fever and malaise can evolve into severe headache, a rigid neck, vomiting and sensitivity to bright – lights → symptoms characteristic of meningitis. Coma can occur within few hours.
2- Septicemia :
Meningococci can cause a life-threatening septicemia in healthy individual in less than 12 hours. Up to 30% of patients with meningitis go on to septicemia, and shock for which the B. endotoxin (LOS) is largely responsible.Acute meningococcal septicemia seen in very young children, characterized by = (1) large purple blotchy skin hemorrhages, (2) vomiting, (3) diarrhea, (4) circulatory collapse, (5) necrosis of adrenals and (6) death with 10 -12 hours.
Laboratory identification
Haematological investigation:Total leukocyte count shows leukocytosis more than 15000.
Differential leukocyte count show increase in polymorphonuclear cells.
CSF examination:
Macroscopically fluid is mild to moderately turbid, contains many pus cells .
One portion of fluid is centrifuged and studied after Gram staining; G - diplococcus, shaped like a kidney bean, appears in pairs inside polymorph (Figure) , nonmotile , piliated , capsulated
The second portion is inoculated on blood agar or chocolate agar under 5 -10% CO 2 ; γ – hemolysis on blood agar .
Identified meningococci on the basis of morphology and biochemicalreactions .
Third portion of CSF is inoculated overnight and then subculture on chocolate agar. This method may succeed when direct method fails.
Blood culture: in early cases of meningitis , culture is positive.
Nasopharyngeal swab: it is useful in carriers.Petechial lesion: collected from petechial haemorrhage.
Autopsy: it is done on meninges (lateral ventricles and surface on brain and spinal cord) within 12 hours of death of patient,after smear and culture organism are identified
Retrospective evidence: demonstrating complement fixing antibodies in sera by latex agglutination or hemaglutination test.
Treatment and Prevention
B. meningitis is a medical emergence, so antibiotic treatment cannot await a definitive bacteriologic diagnosis. High fever, headache and a rash of meningococcal infection are treated immediately to prevent septicemia ( reduces mortality to about 10% as soon as possible treated) . Gram stain on CSF can be performed immediately and latex agglutination tests with serogroup – specific anticapsular antibody can be used to identified N. serogroup in CSF .In past treated with penicillin G or ampicillin in large intravenousdoses ,but resistant strains increasingly common . Cefotaxime or ceftriax one are used.
Prevention by a conjugate meningococcal vaccine (MCV4) for use inadult 11 -55 years of age ( MCV4 is a vaccine that contains capsular from serogroups A, C, W -135, and Y conjugated to diphtheria toxoid ) (Figure 3).
Prophylaxis : Rifampin is used to treat family members of an infected individual to eliminate the carrier state. Oral ciprofloxacin and intramuscular ceftriaxone.
Commensal Neisseria
They may be inhabit normal respiratory tract, their pathogenic significance is uncertain , Neisseria flavescens and Neisseria catarrhalis have been reported occasionally as having caused meningitis.Thanks